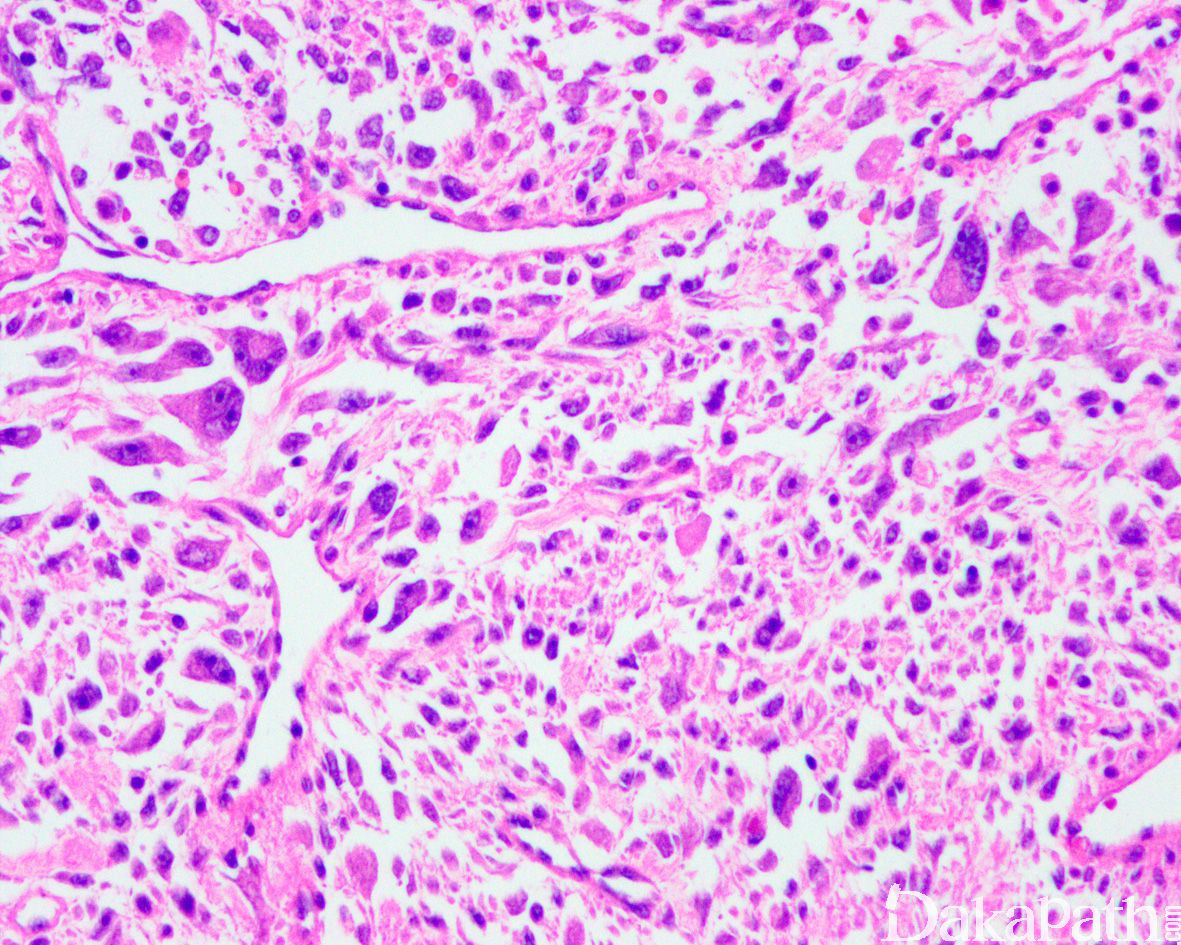
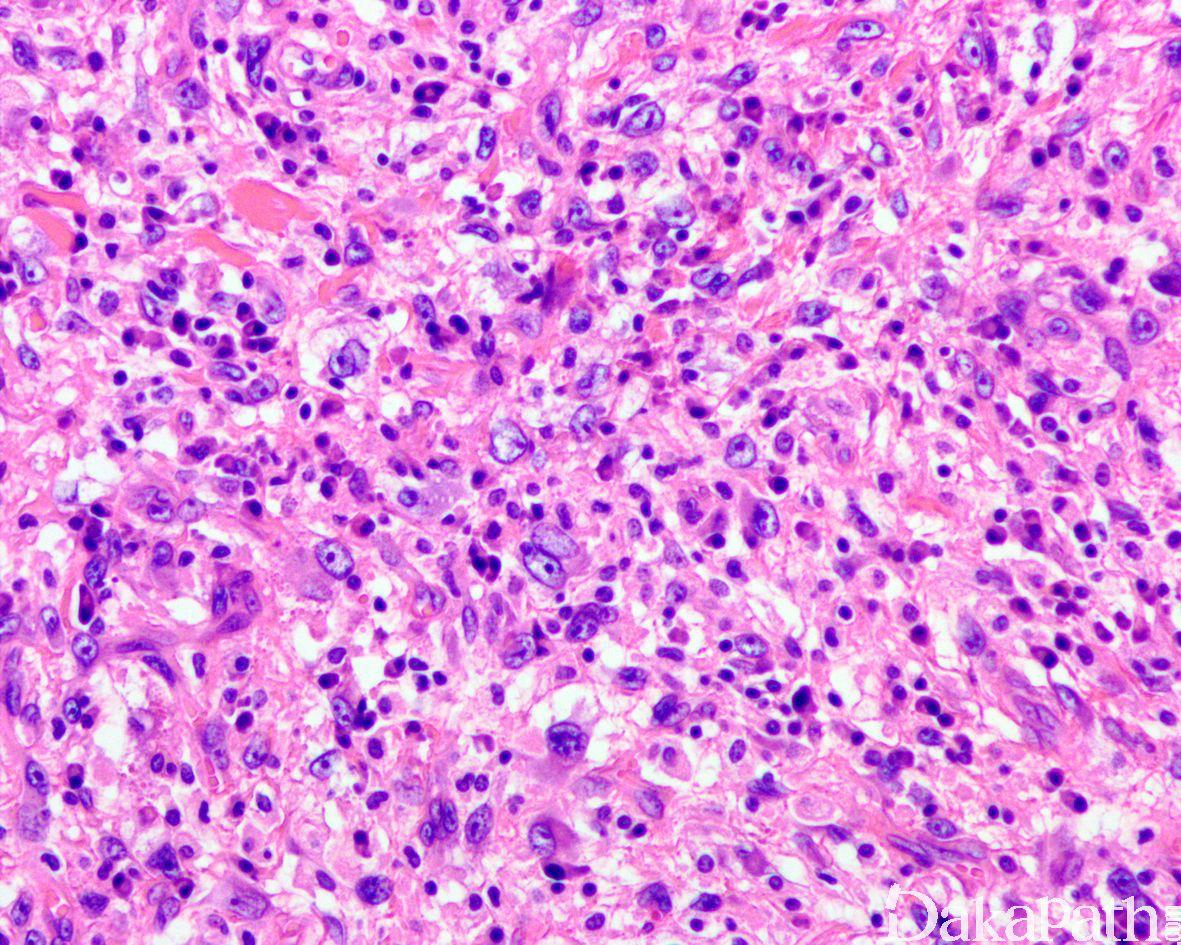
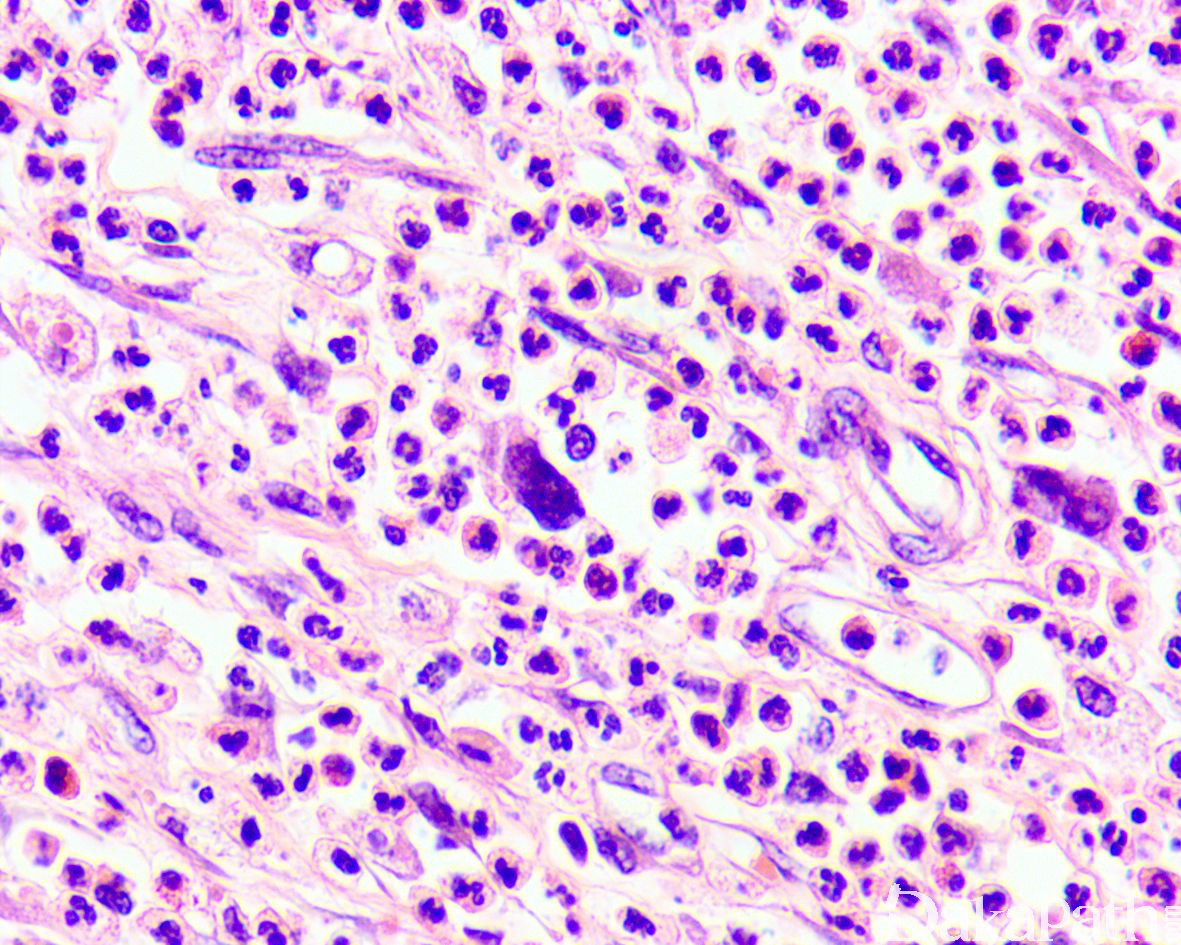

去分化脂肪肉瘤
Dedifferentiated Liposarcoma
同义词(或曾用名): 无
概述:
含有两种不同分化和形态结构的脂肪肉瘤: 分化良好的脂肪瘤样脂肪肉瘤突然转变或逐渐转变为去分化成分即非脂肪性梭形细胞肉瘤。
发病部位: 多发生于盆腔腹膜后、腹股沟和精索旁深部软组织。
诊断要点:
去分化脂肪肉瘤(DDLPS)占所有脂肪肉瘤的 18%,一般定义为非典型脂肪瘤样肿瘤/高分化脂肪肉瘤(ALT/WDLPS)向非脂肪源性的肉瘤成分转化,偶尔去分化转化的成分可为同源性的多形性脂肪肉瘤样。约 90%的去分化发生于原发肿瘤内,即肿瘤一开始就表现为 DDLPS,相对应的约 10%的去分化发生在 ALT/WDLPS 多次复发之后的转化,平均间隔时间约为 7.7 年。DDLPS 好发于中老年人,无性别好发倾向,极罕见发生于儿童和青少年。任何部位的 ALT/WDLPS 均可发生去分化,发生去分化的比例约 10%,但这一比例可能存在评估不足,随着遗传学检测手段的广泛应用,新近较大宗的流行病学证据提示 DDLPS 甚至可能是所有软组织肉瘤中最常见的类型。绝大多数 DDLPS 位于后腹膜和盆腔软组织间隙内,其次为肢体和精索/睾丸旁区,少见的部位包括胸腔、纵隔和头颈部(如喉腔或食管)等。后腹膜区由于存在较大的肿瘤生长空间,该部位的 ALT/WDLPS 可以长期生长而不易引起症状,因而有较高的危险性(约 28%)在诊断时即存在去分化,而肢体部位的 ALT/WDLPS 由于早期即表现为肉眼可见的肿块而进行切除,因此较少发生去分化。DDLPS 的临床表现非特异,较浅表部位的肿瘤常表现为体积较大的缓慢生长的无痛性肿物,较少像去分化癌一样有一个长期缓慢存在的肿块而近期快速生长的过程,若存在则提示可能为 DDLPS;而体腔深部的肿瘤常为影像学检测偶然发现或因压迫周围器官而引起相应的症状。DDLPS 瘤体通常较大(大多数> 10 cm),有时可达 30 cm 以上,部位较深,大体上多为推挤性的多结节状,可见部分包膜。取决于 ALT/WDLPS 和去分化成分的比例以及后者的组织学构成,切面可表现为灰黄质软为主至灰白灰褐色质实为主,两者在大体上的分界一般不如组织学上的分界清楚,黏质感、出血或坏死不少见。后腹膜的 DDLPS 有时可见延续至周围器官而需要进行连带的切除。
如前所述,DDLPS 组织学上通常表现为 ALT/WDLPS 成分向非脂肪源性的肿瘤成分转化,2 种成分在镜下通常分界较清楚,表现为突然的过渡;但有时可表现为逐渐的过渡或在整个肿瘤内交错的分布(马赛克样的去分化),这一情况尤其在伴有低级别去分化时常见。肿瘤可能部分带假包膜或边界清楚,但至少局部可见推挤状或浸润性边界,后腹膜的 DDLPS 常见累及周围实质器官(如肾脏等)。高分化与去分化成分的比例在不同肿瘤内多少不等,有时候即使在广泛取材的情况下高分化成分也可能完全确如,而去分化成分通常较广泛,但有时也可能仅仅不足 1 cm(又称为微小去分化)。DDLPS 中的 ALT/WDLPS 组织学类型以脂肪瘤样和硬化性为主,而去分化成分大多数表现为高级别去分化特征包括高级别多形性肉瘤样(多形性瘤细胞伴有席纹状排列类似于多形性未分化肉瘤/恶性纤维组织细胞瘤)、高级别梭形细胞肉瘤样(细胞密度较高的梭形瘤细胞伴有交错束状或鱼骨样排列类似于纤维肉瘤)以及少见的高级别圆细胞肉瘤样(弥漫的小蓝圆细胞类似于骨外尤文肉瘤或差分化的滑膜肉瘤)和上皮样特征(弥漫成片的上皮样瘤细胞伴有丰富的嗜酸性胞质或横纹肌样特征类似于转移性癌或恶性间皮瘤),高级别去分化成分通常瘤细胞密度高,间质稀少,核分裂象活跃(> 5 个/10 HPF),但比较于与之类似的肿瘤而言,去分化成分的核分裂象相对较少;坏死较为常见。
少数情况下,去分化成分可表现为低级别去分化组织学特征包括低度恶性纤维黏液肉瘤样、纤维瘤病样、炎性肌纤维母细胞瘤样以及孤立性纤维性肿瘤样等,低级别去分化成分瘤细胞以纤维母细胞样细胞为主,密度相对较低,间质较丰富,核异型性轻-中度,核分裂象< 5 个/10 HPF,罕见坏死。在后腹膜和腹部盆腔等部位的 DDLPS 可表现明显的间质黏液变性,特别是低级别 DDLPS,局部的黏液变性可导致稀疏的瘤细胞于血管周聚集从而类似于低级别黏液纤维肉瘤,而广泛的黏液变性导致局部的丛状小血管聚集和肺水肿样组织间隙使得 DDLPS 可能非常类似于黏液样脂肪肉瘤。另一少见而特殊的 DDLPS 特征为脑膜上皮样漩涡伴有化生性的骨形成,组织学上表现为低级别的梭形或胖梭形瘤细胞围绕中央小血管呈同心圆状或洋葱皮样排列,类似于脑膜瘤中常见的漩涡样结构,在漩涡的周围常见伴随的化生性骨形成。该组织学特征常出现在低级别去分化的 DDLPS 中,尽管罕见,但当其出现的时候具有高度的诊断提示作用。
约 5%~ 10%的 DDLPS 可显示异源性的间叶性分化,此类肿瘤在过去可能被诊断为恶性间叶瘤,异源性分化常见为骨、软骨、肌样分化以及少见的血管内皮细胞分化。肌样分化表现为横纹肌肉瘤样和平滑肌肉瘤样特点,多发生在后腹膜和睾丸旁等部位,横纹肌肉瘤样 DDLPS 通常为高级别去分化,而平滑肌肉瘤样 DDLPS 既可为高级别也可为低级别去分化。在非常罕见的情况下,DDLPS 可出现异源性的上皮性去分化,除了表现为上皮样瘤细胞特征之外,尚表达细胞角蛋白。尽管大多数 DDLPS 的去分化成分为非脂肪源性肉瘤,少数去分化可为同源性的脂肪肉瘤,组织学表现为低级别或高级别的去分化肉瘤中可见散在或局灶成片的多形性脂肪母细胞,类似于多形性脂肪肉瘤。
如上所述,DDLPS 可显示相当宽阔的组织学形态谱,除了上述介绍的常见与其他类型软组织肉瘤相似的组织学特点之外,尚可见许多形态学难以描述的结构特点。后腹膜部位之外的 DDLPS 可模拟该部位更常见的软组织肿瘤从而造成鉴别诊断混淆,如食管黏膜下的 DDLPS 可能模拟更常见的胃肠道间质肿瘤或炎性纤维性息肉,睾丸旁的 DDLPS 可能类似于细胞性血管纤维瘤等。多数 DDLPS 常见上述提及的多种组织学构型,而高级别去分化有时可与低级别去分化共存。

免疫组织化学染色:
免疫组织化学染色,绝大多数的 DDLPS 弥漫强表达 p16 蛋白(核和质表达),是诊断 DDLPS 最敏感的标志物,但缺乏特异性,许多与之形态学相似的肿瘤,特别是高级别肿瘤(如平滑肌肉瘤和肉瘤样癌等)亦可弥漫表达 p16。由于 DDLPS 一致性的存在 12q14-15 区域的扩增和过表达,而 MDM2 蛋白和 CDK4 蛋白的强表达与相应的基因扩增存在高度的一致性,因此免疫组织化学染色 MDM2 和 CDK4 的共表达(均为弥漫核表达)对于诊断 DDLPS 具有较大的帮助。在与 ALT/WDLPS 之外的其他类型的脂肪源性肿瘤的鉴别诊断中,联合应用 p16. MDM2 和 CDK4 对于诊断 DDLPS 具有高度的敏感性和特异性,93%的 DDLPS 表达上述 3 个标志物中的至少 2 个,72%表达全部 3 个标志物。但在 DDLPS 与非脂肪源性的肿瘤鉴别诊断时,上述 3 个标志物的特异性则明显不够;此时,应用荧光原位杂交(FISH)检测 MDM2 基因的扩增对于诊断 DDLPS(在适当的组织学背景下)具有高度的特异性和敏感性,尤其是在小活检标本、未见典型的 ALT/WDLPS 成分、低级别去分化和少见特殊类型的 DDLPS 诊断时更是如此。MDM2 基因的扩增目前普遍认为是诊断 ALT/WDLPS 和 DDLPS 的金标准,需要指出的是,MDM2 基因扩增并非 ALT/WDLPS 和 DDLPS 所特有,其他常见存在 MDM2 基因扩增的肿瘤还包括低级别中央型骨肉瘤、骨旁骨肉瘤以及原发的心脏内膜肉瘤等。约半数左右的 DDLPS 可局灶或弥漫表达 CD34,去分化成分一般不表达 S100 蛋白,伴有肌纤维母细胞分化者可表达 SMA 和 MSA 或结蛋白[23],伴有横纹肌和平滑肌分化者可分别表达 MyoD1 和 H-caldesmon,具有脑膜上皮瘤样漩涡特征的 DDLPS 可表达 SMA 和 Claudin-1 提示其肌纤维母细胞或神经束膜分化的特征。新近发现,约 6%的 DDLPS 可见 H3k27me3 的表达缺失易与恶性外周神经鞘膜瘤(MPNST)混淆,约 11%的 DDLPS 可见 STAT6 基因扩增从而局灶或弥漫表达 STAT6 易误诊为孤立性纤维性肿瘤(SFT)。
分子标记:
MDM2 扩增;12q13-15 区域扩增;CDK4, HMGA2 扩增;6q23(ASK1 基因)和 1p32(c-JUN 基因)的共扩增
鉴别诊断:
高级别 DDLPS 的鉴别诊断:所有位于后腹膜和睾丸旁的、组织学表现为多形性未分化肉瘤样的肿瘤,无论小活检还是切除标本均应首先考虑高级别 DDLPS 直至证明不是,极少数一部分可能是转移性的多形性未分化肉瘤或多形性肉瘤样癌,与后两者相比,DDLPS 的多形性瘤细胞分布相对较局限,瘤巨细胞相对较少,核分裂象也相对少见,广泛的取材寻找 WDLPS 成分,应用免疫组织化学染色和 MDM2 的 FISH 检测可助于其诊断。对于周围型(肢体、躯干和头颈部等部位)多形性未分化肉瘤样肿瘤,也应积极的行上述手段以排除 DDLPS 的可能。具有高级别梭形细胞肉瘤特征的 DDLPS 需要与单相梭形细胞性滑膜肉瘤、胃肠道间质肿瘤(GIST)以及 MPNST 等鉴别。滑膜肉瘤的瘤细胞相对一致,无高级别 DDLPS 常见的多形性,免疫组织化学染色至少局灶表达上皮性标志物,遗传学上存在特征性的 SS18 基因重排;GIST 特别是与 PDGFRA 突变相关的上皮样特征为主的 GIST,常见于肠系膜等部位,组织学上可见非典型核以及空泡状胞质类似于脂肪母细胞,免疫组织化学染色亦表达 CD34,因此有时可与 DDLPS 混淆,GIST 弥漫表达 DOG1 而 DDLPS 通常阴性,也未见 MDM2 的表达和扩增。MPNST 通常与神经纤维瘤病相关或起源于大神经,组织学上常见富于细胞区与少细胞区呈大理石样的镶嵌状分布,瘤细胞易于向血管腔内生长,至少局灶显示两端逐渐变细和弯曲的核特征。尽管 H3K27me3 的表达缺失是诊断 MPNST 高度敏感而特异性的标志物,如前所述,约 6%的 DDLPS 也可见 H3k27me3 的表达缺失,因此单纯应用此标志物可能无助于两者的区分。MPNST 局灶表达 S-100 蛋白或 SOX10,约 35%可表达 MDM2,但极罕见存在 MDM2 基因的扩增。较罕见情况下,高级别 DDLPS 可表现上皮样特征并表达上皮性标志物,多发生于腹膜后,瘤细胞成片排列具有丰富的嗜酸性胞质或横纹肌样瘤细胞特征,特别易误诊为低分化癌或恶性间皮瘤,存在 ALT/WDLPS 成分、MDM2 过表达和基因扩增可资鉴别。伴有异源性肌性分化的 DDLPS 分别需要与纯的平滑肌肉瘤或横纹肌肉瘤等鉴别。平滑肌肉瘤样 DDLPS 常见于后腹膜,广泛取材通常可见多少不等的 ALT/WDLPS 成分与平滑肌肉瘤样成分过渡,这种组织学表现有时可能会误认为是平滑肌肉瘤在脂肪组织内的浸润性生长,此外常可见非平滑肌源性的梭形细胞或多形性非特异性肉瘤成分等,而真正的平滑肌肉瘤多为推挤状的膨胀性生长,较少出现脂肪组织内的浸润,组织学和免疫表型上通常表现为纯的平滑肌分化。平滑肌肉瘤样 DDLPS 还需要与所谓的脂肪平滑肌肉瘤鉴别,后者认为是 WDLPS 伴有高分化平滑肌肉瘤分化,两肿成分相互交错分布,核分裂象少见,常见壁内含有深染异型细胞的厚壁大血管,预后较 DDLPS 好。平滑肌肉瘤可弥漫表达 p16,较广泛的表达 CD34 和 MDM2,但无 MDM2 基因的扩增。具有同源性的多形性脂肪母细胞分化的 DDLPS 需要与真正的多形性脂肪肉瘤鉴别,后者的预后明显较前者差,前者多见于后腹膜,而后者主要发生在肢体和躯干,极少见于后腹膜;组织学上,前者的多形性脂肪母细胞通常散在或仅局灶成片分布,而后者的多形性脂肪母细胞的多形性更明显,分布也更弥漫;更重要的是,前者一致性的弥漫表达 MDM2 和 CDK4,均存在 MDM2 基因扩增,而后者显示复杂性的核型,无 MDM2 基因扩增。
低级别 DDLPS 的鉴别诊断:包括硬化性 WDLPS、“梭形细胞 WDLPS”,侵袭性纤维瘤病、炎性肌纤维母细胞瘤、SFT 等,具有广泛黏液变性的低级别 DDLPS 需要与低级别黏液纤维肉瘤和黏液性脂肪肉瘤等区分。硬化性 WDLPS 有时候可能较难与低级别 DDLPS 区分,主要依靠组织学特征来进行鉴别。一般来说,硬化性 WDLPS 的瘤细胞相对更稀疏但多形性较明显,核分裂象较少见,与不成熟的脂肪细胞之间以混杂分布为主,基质较丰富呈硬化的纤维状;而低级别 DDLPS 的瘤细胞以较明显的束状排列为主,多形性轻-中度,核分裂象相对较多见,基质呈纤维黏液样。必须指出的是,有时候区分这两者可能存在较大的主观性。“梭形细胞 WDLPS”又称为不典型梭形细胞脂肪瘤样肿瘤,主要发生在肢体和头颈部,极罕见于后腹膜,组织学上表现为梭形细胞脂肪瘤样的组织学背景中出现浸润性生长和单泡或多泡状的脂肪母细胞,该肿瘤实际上与一般的 ALT/WDLPS 在遗传学上是完全不同的一类脂肪肿瘤,主要表现为 RB 基因丢失而无 MDM2 基因的扩增,更接近于梭形细胞脂肪瘤,免疫组织化学染色多表达 CD34,特征性的表现为 RB1 蛋白表达缺失,不表达 p16. MDM2 和 CDK4。侵袭性纤维瘤病浸润周围的脂肪组织时可导致后者退变进而表现出假脂肪母细胞性的特征,因而可能会与低级别 DDLPS 混淆,核表达 β-catenin 可资鉴别。具有肌纤维母细胞分化特征的 DDLPS 可误认为是炎性肌纤维母细胞瘤,ALK 蛋白过表达和基因重排检测可助于鉴别诊断。显示明显的血管外皮瘤样结构的低级别 DDLPS 可与 SFT 混淆,如前所述,两者均可表达 CD34 和 STAT6 可进一步造成鉴别诊断困惑,与 DDLPS 不同,SFT 表达 CD34 和 STAT6 更强而弥漫,此外尚可表达 bcl-2 和 CD99,SFT 表达 STAT6 是基于特征性的 NAB2-STAT6 基因融合,而 DDLPS 表达 STAT6 则是归因于 STAT6 基因的扩增。区分广泛黏液变性的 DDLPS 与黏液样脂肪肉瘤具有重要的临床病理意义,两者是遗传学特征和生物学行为完全不同的脂肪肉瘤亚型。原发于后腹膜的黏液样脂肪肉瘤非常罕见,之前多数诊断的此类肿瘤大多数可能是广泛黏液变性的 WDLPS 或 DDLPS,极少数可能是肢体部位的黏液样脂肪肉瘤转移而来。与 DDLPS 不同,黏液样脂肪肉瘤的丛状血管分布更弥漫,瘤细胞以圆形为主而非梭形,多形性不明显,遗传学显示特征性的 DDIT3/CHOP 基因重排,不表达 P16. MDM2 和 CDK4,无 MDM2 基因的扩增。值得注意的是,新近的研究发现约 33%的 DDLPS 除了存在 MDM2 基因扩增之外另可见 DDIT3/CHOP 基因扩增而非重排,伴有 DDIT3/CHOP 基因扩增的 DDLPS 组织学上常见表现为黏液样脂肪肉瘤样形态或伴有同源性的多形性脂肪母细胞特征,因此,在应用 FISH 检测进行鉴别诊断时应予以警惕。
预后:
总体来说 DDLPS 是一种中到高级别的肉瘤,局部复发率约 41%,远处转移率 15%~ 30%,肿瘤相关的死亡率约 28%,但相比较于其他类型的多形性肉瘤来说,DDLPS 的预后仍然相对较好。决定预后最重要的因素是肿瘤的发生部位,位于后腹膜的肿瘤与发生在其他部位的肿瘤相比明显具有较差的预后和总体生存率。 仅有“微小去分化”(去分化肿瘤的直径< 1 cm)的肿瘤相比于去分化成分> 1 cm 的肿瘤预后较好。早期的研究表明去分化成分的分级与肿瘤的总体预后之间并无联系,但新进的回顾性研究证实去分化成分的组织学分级与疾病特异的存活率和无局部复发的存活率均存在相关性,低级别的 DDLPS 与高级别 DDLPS 相比具有较好的预后。其他提示预后较差的病理因素包括后腹膜的 DDLPS 存在横纹肌母细胞分化和上皮性分化等。DDLPS 伴有骨源性分化(无论骨的分化是否成熟)往往提示肿瘤可能会出现早期复发,但并不影响总体的预后。
治疗:
根治性的手术切除是改善预后最重要的手段,有时候需要联合多脏器的切除,对于复发的病例可采用局部放疗,DDLPS 对化疗敏感性较差。
参考文献:
赵明,徐明鑫,王宇彬,何向蕾. 去分化脂肪肉瘤的组织学诊断与鉴别诊断. 中华病理学杂志. 2019; 48(7):573-9.
